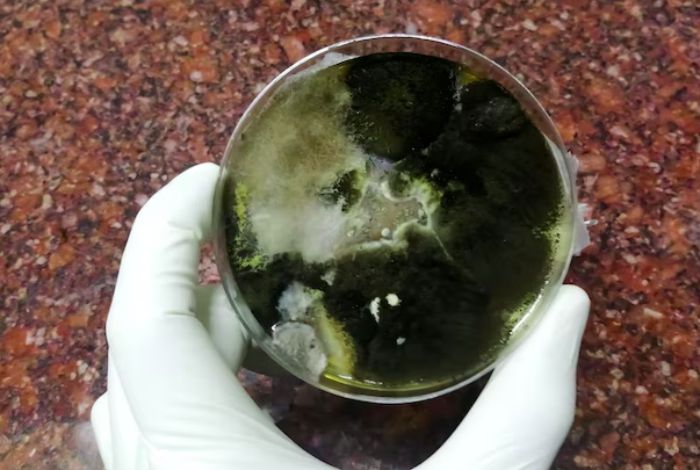
karakteristik bakteri tinja

Blog
Panduan Lengkap Memilih Bakteri Pengurai Limbah Terbaik
Sebagai pemilik rumah, menjaga sistem pembuangan limbah agar berfungsi optimal adalah keharusan. Salah satu komponen kunci dalam sistem ini adalah septic tank. Namun, seiring waktu, masalah seperti bau tidak sedap, saluran mampet, atau bahkan luapan bisa terjadi. Dalam pencarian solusi, Anda mungkin sering mendengar istilah bakteri pengurai septic tank sebagai jawaban “ajaib”. Tapi, apa sebenarnya produk ini dan apakah ia benar-benar bisa menggantikan kebutuhan sedot WC?
Artikel ini akan mengupas tuntas segala hal yang perlu Anda ketahui tentang bakteri pengurai, mulai dari cara kerjanya, manfaat nyata, hingga kapan Anda tetap harus memanggil jasa sedot WC profesional. Tujuannya adalah memberikan Anda wawasan lengkap agar Anda dapat membuat keputusan yang tepat untuk perawatan septic tank Anda.
Apa Sebenarnya Bakteri Pengurai Septic Tank Itu?
Secara sederhana, septic tank Anda adalah sebuah ekosistem mini. Di dalamnya, hidup berbagai jenis mikroorganisme atau bakteri alami yang bertugas “memakan” atau mengurai limbah organik (tinja, sisa makanan, kertas toilet) yang masuk.
Namun, ekosistem ini sangat rapuh. Penggunaan sabun cuci, deterjen, pemutih, atau bahan kimia rumah tangga lainnya yang berlebihan dapat membunuh bakteri-bakteri baik ini. Akibatnya, proses penguraian melambat, dan limbah padat (lumpur atau sludge) menumpuk lebih cepat di dasar tangki.
Di sinilah produk bakteri pengurai septic tank berperan. Produk ini adalah konsentrat bakteri “baik” (biasanya dalam bentuk bubuk atau cair) yang sengaja ditambahkan kembali ke dalam septic tank Anda untuk memperkuat dan memulihkan koloni bakteri alami yang mungkin telah mati.
Membedah Cara Kerja Bakteri Pengurai Septic Tank
Saat Anda menuangkan produk bakteri pengurai ke dalam kloset, Anda sebenarnya sedang melepaskan miliaran “pekerja” baru ke dalam sistem. Berikut adalah tahapan Data cara kerja bakteri pengurai septic tank:
- Fase Aktivasi: Bakteri yang tadinya dalam keadaan “tidur” (dorman), terutama yang berbentuk bubuk, akan aktif kembali begitu bersentuhan dengan air dan limbah (sumber makanan mereka).
- Produksi Enzim: Bakteri ini akan melepaskan enzim-enzim khusus (seperti Lipase, Protease, Amilase). Enzim ini berfungsi seperti “pisau dan garpu”, memecah molekul limbah organik yang kompleks (lemak, protein, karbohidrat) menjadi ukuran yang lebih kecil dan lebih sederhana.
- Fase Konsumsi: Setelah limbah terpecah, bakteri akan mengonsumsi atau “memakan” partikel-partikel kecil tersebut sebagai sumber energi untuk berkembang biak.
- Hasil Akhir: Proses metabolisme bakteri ini mengubah limbah padat organik menjadi komponen yang lebih sederhana dan tidak berbahaya, seperti air (H2O), karbon dioksida (CO2), dan gas metana (CH4) yang akan keluar melalui pipa ventilasi.
Hasilnya, volume lumpur padat organik di dasar tangki berkurang, dan air olahan (effluent) yang keluar menuju bidang resapan menjadi jauh lebih bersih dan tidak berbau.
Berapa Lama Bakteri Pengurai Bekerja?
Ini adalah pertanyaan penting. Berapa lama bakteri pengurai bekerja sangat bergantung pada kondisi septic tank dan kualitas produk. Jangan berharap hasil instan dalam semalam. Bakteri membutuhkan waktu untuk berkembang biak dan beradaptasi. Umumnya, Anda mungkin baru akan merasakan pengurangan bau dalam 1-2 minggu, tetapi untuk pengurangan volume lumpur yang signifikan, dibutuhkan pemakaian rutin selama beberapa bulan.
Manfaat Bakteri Pengurai Limbah (Jika Digunakan Rutin)
Menggunakan bakteri pengurai secara teratur bukanlah solusi instan, melainkan bagian dari perawatan preventif. Berikut adalah manfaat bakteri pengurai limbah yang sesungguhnya:
- Mengurangi Bau Tidak Sedap: Dengan mengurai limbah penyebab bau (seperti H2S atau amonia) secara efektif, bakteri ini secara signifikan mengurangi atau menghilangkan aroma tak sedap yang sering keluar dari saluran pembuangan.
- Mencegah Penumpukan Lumpur (Sludge): Manfaat utamanya adalah memperlambat laju penumpukan lumpur organik di dasar tangki. Ini berarti septic tank Anda tidak akan cepat penuh.
- Mencegah Saluran Mampet: Bakteri ini juga membantu mengurai lemak dan minyak yang seringkali menjadi biang kerok mampetnya pipa pembuangan, terutama dari wastafel cuci piring.
- Memperpanjang Usia Bidang Resapan: Air olahan yang lebih bersih berarti lebih sedikit partikel padat yang lolos dan menyumbat pori-pori tanah di bidang resapan. Ini sangat penting, karena memperbaiki bidang resapan biayanya sangat mahal.
- Menjaga Keseimbangan Ekosistem: Produk ini memulihkan keseimbangan alami septic tank Anda yang mungkin terganggu oleh bahan kimia rumah tangga.
Panduan Memilih Bakteri Pengurai Septic Tank Terbaik
Pasar dibanjiri oleh berbagai merek, yang membuat konsumen bingung saat mencari bakteri pengurai septic tank terbaik. Berikut adalah beberapa faktor yang perlu Anda pertimbangkan:
1. Bentuk Produk: Bubuk vs. Cair
- Bubuk: Umumnya memiliki konsentrasi bakteri yang lebih tinggi dan masa simpan yang lebih lama. Bakteri dalam keadaan dorman dan baru aktif saat terkena air. Dianggap lebih cost-effective.
- Cair: Bakteri sudah dalam keadaan aktif, namun mungkin memiliki masa simpan lebih pendek dan konsentrasi yang tidak setinggi bubuk.
2. Jenis Bakteri (Strain)
Cari produk yang mengandung campuran berbagai jenis bakteri (multi-strain) dan enzim. Pastikan produk tersebut mengandung bakteri anaerobik, yaitu bakteri yang dapat hidup dan bekerja efektif di lingkungan minim oksigen seperti di dalam septic tank.
3. Konsentrasi Bakteri (CFU)
Efektivitas produk sering diukur dalam CFU (Colony Forming Units) per gram atau per mililiter. Semakin tinggi angkanya, semakin banyak bakteri aktif yang Anda dapatkan, yang berarti proses penguraian bisa berjalan lebih cepat.
4. Ulasan dan Keamanan
Selalu periksa ulasan dari pengguna lain. Pilih produk dari produsen tepercaya yang mencantumkan dengan jelas bahwa produknya aman untuk sistem perpipaan, lingkungan, dan tidak mengandung bahan kimia keras berbahaya.
Kisaran Harga Obat Pengurai Tinja Septic Tank
Membahas harga obat pengurai tinja septic tank, variasinya sangatlah luas. Harga dipengaruhi oleh merek, konsentrasi (CFU), dan ukuran kemasan. Produk ini tidak harus mahal untuk menjadi efektif.
Di pasaran, Anda dapat menemukan produk mulai dari harga puluhan ribu rupiah untuk kemasan sekali pakai atau saset kecil, hingga ratusan ribu rupiah untuk kemasan yang lebih besar (seperti 1 kg bubuk atau 1 liter cairan) yang dapat digunakan untuk perawatan selama beberapa bulan. Sebaiknya bandingkan harga per dosis atau per gram untuk mendapatkan nilai terbaik, bukan hanya melihat harga kemasan.
PENTING: Keterbatasan Bakteri Pengurai
Di sinilah letak kesalahpahaman terbesar. Bakteri pengurai adalah produk perawatan yang hebat, tetapi mereka bukan pengganti jasa sedot WC profesional. Bakteri memiliki keterbatasan yang jelas:
- Tidak Mengurai Sampah Anorganik: Bakteri hanya memakan limbah organik. Mereka tidak bisa mengurai tisu basah, pembalut wanita, puntung rokok, plastik, atau sampah non-organik lainnya yang sering terlanjur masuk ke kloset. Sampah ini akan tetap menumpuk di dasar tangki.
- Tidak Mengatasi Tangki yang Sudah Penuh: Jika septic tank Anda sudah penuh hingga air meluap ke kloset, menambahkan bakteri tidak akan menyelesaikan masalah. Volume air dan lumpur anorganik yang sudah ada terlalu banyak. Menambahkan bakteri ibarat mencoba mengosongkan kolam dengan ember bocor.
- Tidak Memperbaiki Masalah Struktural: Jika masalah Anda adalah bidang resapan yang sudah jenuh (jenuh air tanah) atau tangki yang bocor, bakteri tidak dapat memperbaikinya.
Kapan Anda Tetap Membutuhkan Jasa Sedot WC?
Anda tetap mutlak membutuhkan jasa sedot WC profesional dalam situasi berikut:
- Saat Sudah Terlanjur Penuh: Jika air sudah meluap atau tidak bisa surut, ini adalah tanda darurat. Satu-satunya solusi adalah penyedotan fisik untuk mengosongkan tangki.
- Untuk Menguras Limbah Anorganik: Hanya penyedotan yang dapat mengangkat tumpukan sampah non-organik (tisu basah, plastik, dll.) yang tidak bisa diurai bakteri.
- Sebagai Perawatan Rutin Terjadwal: Aturan emas untuk septic tank adalah menyedotnya secara rutin setiap 2 hingga 5 tahun sekali, tergantung pada ukuran tangki dan jumlah penghuni rumah. Ini adalah cara terbaik untuk mereset sistem dan memastikan tangki berfungsi panjang umur.
Kesimpulannya, gunakan bakteri pengurai septic tank sebagai “suplemen” rutin bulanan untuk menjaga kesehatan septic tank Anda, memperlambat penumpukan lumpur, dan menghilangkan bau. Namun, jangan pernah lupakan “check-up” utama, yaitu penyedotan profesional terjadwal. Menggabungkan kedua metode ini adalah cara paling cerdas dan hemat biaya untuk sistem pembuangan yang bebas masalah.
Jika septic tank Anda sudah menunjukkan tanda-tanda penuh atau Anda sudah bertahun-tahun tidak melakukan penyedotan, jangan ambil risiko. Sudah saatnya memanggil para ahli di sedot wc resmi. Sebagai bagian dari jaringan sedot wc resmi yang melayani seluruh Indonesia, kami tidak hanya menjual janji, tetapi memberikan solusi nyata dan tuntas untuk masalah limbah Anda.
- Profesional dan Berpengalaman => Tim kami telah melalui pelatihan ketat dan memiliki jam terbang tinggi dalam menangani berbagai kasus sumbatan, dari yang ringan hingga yang terparah.
- Layanan Resmi Di Indonesia dan mempunyai legalitas => Kami adalah perusahaan berbadan hukum, bukan perorangan, yang memberikan jaminan keamanan dan profesionalisme dalam setiap layanan.
- Tarif Termurah sesuai budget => Kami menawarkan harga yang sangat kompetitif dan transparan, disesuaikan dengan tingkat kesulitan pekerjaan, tanpa mengorbankan kualitas.
- Jaminan Bersih Tanpa Biaya Tambahan => Harga yang disepakati adalah harga final. Tidak ada biaya tersembunyi atau tambahan tak terduga setelah pekerjaan selesai.
- Konsultasi Gratis 24 Jam => Hubungi kami kapan saja, siang atau malam, untuk berkonsultasi mengenai masalah Anda. Tim kami siap menjawab tanpa biaya.
- Tuntas Bergaransi => Kami tidak hanya membersihkan, kami menyelesaikan masalah. Layanan kami didukung garansi resmi untuk memastikan Anda puas dan masalah tidak kembali.